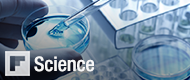

Flipboard is
Your Personal Magazine

Millions of people use Flipboard to read and collect the news they care about, curating their favorite stories into their own magazines on any topic imaginable. Now magazines created by our readers, from Dali to End Trafficking, can be shared and enjoyed on the Web by anyone, anywhere.
Tap or click any cover above or explore more great magazines here.

Flipboard is your personal magazine, filled with the things you care about. Catch up on the news, discover amazing things from around the world, or stay connected to the people closest to you—all in one place.

Search for anything—people, topics, hashtags, your favorite sites—and then flip through articles, updates, photos and videos all in a beautiful magazine-style format.
* Learn how to make magazines in our new Skillshare class.
Save your favorite stories, photos and videos from across the web. Then create your own beautiful magazines on any topic from Mid Century Design to Italian Cooking to Gadgets I Love.
With our "Flip It" Web bookmarklet you can create magazines and add even more of your favorite content from the Web to your Flipboard. Flipboard Editor allows you to manage your magazines from a convenient dashboard. Rearrange and delete items, set covers and share your magazines with friends—all from the Web.
From the famous to just the fabulously obsessed, Flipboard users from all over the world have made their own unique magazines. Topics range from new technology to vintage motorcycles—follow your favorites and share with friends.